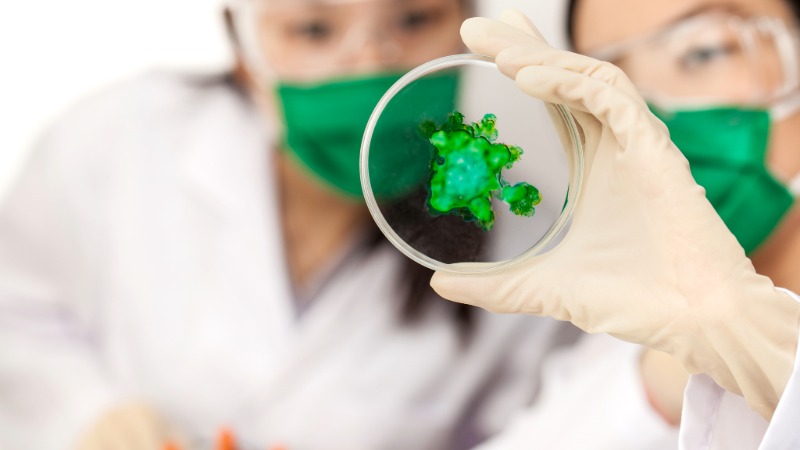
Cientificos trabajando en biomateriales

Innovar no significa únicamente soñar con grandes ideas capaces de transformar mercados, sino llevarlas a cabo y generar un valor real.
Desde la rueda hasta los biomateriales, la historia del desarrollo humano está ligada a la capacidad de transformar la materia. Hoy, la innovación material implica cuestionar el origen, el impacto ambiental y el significado cultural de aquello con lo que diseñamos.
¿Querés saber sobre la innovación material y sus aplicaciones a todo tipo de proyectos creativos?
Conocé más sobre la Licenciatura en Diseño Industrial
Innovación material en el diseño contemporáneo
La innovación material es el proceso de investigación, desarrollo y aplicación de nuevos materiales para generar soluciones con mayor valor funcional, estético, ambiental o tecnológico.

Explorando nuevas combinaciones, procesos productivos y usos, se transforma la manera en que diseñamos y habitamos el mundo. Los materiales constituyen el punto de partida en el proceso de diseño.
Para cualquier proyecto tangible, diseñar desde la materia implica considerar distintos enfoques:
- Material como tecnología: El foco está en mejorar la resistencia, flexibilidad, peso, durabilidad o capacidad de adaptación, utilizando compuestos ultralivianos, polímeros biodegradables o materiales con memoria de forma.
- Material como narrativa: Un objeto fabricado con plástico reciclado transmite valores distintos a uno producido con mármol extraído. Se dan nuevos significados a los residuos y nuevos valores a técnicas tradicionales.
- Material como experiencia sensorial: Texturas, transparencias, temperatura, sonido y tacto influyen en cómo percibimos los objetos y los espacios.
- Material como sistema: Los materiales forman parte de redes productivas, cadenas de suministro y ciclos de vida, por lo que la innovación implica pensar en economía circular, reutilización y reducción de impacto ambiental.
Según el artículo Materials and tools as catalysts of invention in graphic design ideation, la alfabetización material sugiere que los materiales no constituyen solamente soportes físicos, sino recursos expresivos con capacidad propia para estructurar y guiar el pensamiento de diseño.
Funcionan como un lenguaje en sí mismo dentro del proceso creativo.
Cuando el diseñador trabaja desde el material, es capaz de comprender sus propiedades físicas, su ciclo de vida, su impacto ambiental y su potencial expresivo.
Materiales como la piedra, el metal, el vidrio y el plástico definieron épocas, y trajeron nuevas formas de usar, producir y comunicar, ampliando los límites del diseño contemporáneo.
Nuevos materiales como motor creativo
Cada avance en compuestos, biofabricación o nanotecnología abre nuevas posibilidades que antes no existían, permitiendo que sus propiedades estructurales o sensoriales guíen la forma final del producto.

En el diseño contemporáneo, ciencia, tecnología y creatividad convergen en la exploración, convirtiendo a los materiales en los nuevos catalizadores del proceso creativo.
El descubrimiento o desarrollo de un material puede desencadenar el concepto del proyecto.
Este cambio de enfoque transforma la práctica del diseño en varios niveles:
- Amplía el repertorio: Materiales ultralivianos, compuestos híbridos o superficies maleables permiten estructuras más delgadas, orgánicas o dinámicas.
- Habilita nuevas experiencias de uso: Textiles técnicos, superficies flexibles o materiales translúcidos modifican la interacción entre usuario y objeto, volviendo el diseño más inmersivo y sensorial.
- Impulsa modelos alternativos: La aparición de materiales reciclados avanzados, bioplásticos o compuestos de origen orgánico permite pensar en procesos más sostenibles y descentralizados.
La materia deja de ser un recurso pasivo para convertirse en una fuerza activa que condiciona decisiones estéticas, funcionales y productivas.
De esta manera, el diseño basado en materiales no solo responde a necesidades técnicas o ambientales, sino que redefine los límites de lo posible. La capacidad de investigar, experimentar y descubrir posibilidades en la materia transforma la manera en la que se experimenta el diseño.
¿Querés saber sobre la innovación material y sus aplicaciones a todo tipo de proyectos creativos?
Conocé más sobre la Licenciatura en Diseño Industrial
El poder de los biomateriales
En el marco de la innovación material, los biomateriales ocupan un lugar central, que posiciona a la naturaleza como aliada estratégica en el diseño contemporáneo.
Se trata de materiales desarrollados a partir de recursos biológicos cuya misma existencia lleva a repensar la relación entre diseño y naturaleza.
Hongos, algas, bacterias o residuos agrícolas ofrecen alternativas renovables o biodegradables frente a materiales sintéticos tradicionales.
Entre los desarrollos más relevantes se encuentran:
- Micelio: Estructura radicular de los hongos, de bajo consumo energético y puede cultivarse a partir de desechos orgánicos. Es utilizado para crear paneles, envases o piezas estructurales livianas.
- Bioplásticos: Elaborados a partir de almidón, celulosa, algas o residuos agroindustriales. Buscan reemplazar plásticos derivados del petróleo, reduciendo la dependencia de recursos fósiles.
- Cuero vegetal y materiales alternativos: Desarrollados a partir de hojas de piña, cactus, hongos u otros cultivos. Permiten explorar nuevas estéticas y reducir el impacto ambiental de la industria textil.
A diferencia de los materiales industriales convencionales, los biomateriales muchas veces no se “fabrican” en el sentido tradicional, sino que se cultivan.
Este cambio de lógica productiva transforma profundamente el rol del diseñador. Pasa de ensamblar componentes a intervenir en procesos biológicos, considerando cuestiones como temperatura, humedad o nivel de sustrato.
Trabajar con materiales vivos o biodegradables obliga a pensar en ciclos de vida completos.
El objeto deja de concebirse como algo permanente y se integra a una lógica circular donde se considera una perspectiva regenerativa.
En lugar de extraer y descartar, se propone cultivar y reintegrar.
Materiales inteligentes
Si los biomateriales replantean el origen y el ciclo de vida de los objetos, los materiales inteligentes redefinen su comportamiento.

Son sustancias avanzadas capaces de reaccionar ante estímulos externos, como la luz, temperatura, presión o electricidad.
Se modifican algunas de sus propiedades físicas sin necesidad de mecanismos adicionales complejos.
Estos materiales incorporan en su propia composición la capacidad de transformación. Pueden cambiar de color, forma, rigidez o conductividad según el entorno, lo que abre nuevas posibilidades en diseño industrial, moda y tecnología aplicada.
Entre los principales tipos de materiales inteligentes se encuentran:
- Materiales con memoria de forma: Aleaciones o polímeros que recuperan su forma original tras ser deformados al exponerse a determinada temperatura. Se utilizan en dispositivos médicos y componentes industriales.
- Materiales termoactivos y fotocromáticos: Superficies que cambian de color o transparencia según la temperatura o la incidencia de luz. Permiten desarrollar pantallas dinámicaso textiles interactivos.
- Materiales piezoeléctricos: Generan electricidad cuando reciben presión o vibración.
- Superficies autorreparables: Materiales capaces de “cerrar” pequeñas fisuras o daños, extendiendo la vida útil de los productos y reduciendo la necesidad de reemplazo.
La incorporación de materiales inteligentes transforma la relación entre objeto y usuario.
Un espacio puede regular su temperatura de manera pasiva. Una prenda puede adaptarse a cambios climáticos. Una estructura puede responder a condiciones ambientales extremas. Así, el diseño se vuelve más sensible, adaptable y eficiente.
¿Querés saber sobre la innovación material y sus aplicaciones a todo tipo de proyectos creativos?
Conocé más sobre la Licenciatura en Diseño Industrial
Sostenibilidad e innovación material
La crisis ambiental y la escasez de recursos impulsan a diseñadores a replantear el ciclo de vida de los materiales, desde su extracción hasta su disposición final.

Más allá de cuestiones sobre estética o funcionalidad, reducir el impacto ambiental y promover sistemas circulares son los nuevos objetivos de los diseñadores.
El desafío ya no es solo crear materiales más resistentes o estéticos, sino responsables.
La sostenibilidad aplicada a la materia transforma la práctica en dimensiones concretas:
- Evaluación integral del ciclo de vida: La selección de materiales incorpora métricas técnicas que consideran extracción, procesamiento, transporte, uso y fin de vida.
- Descarbonización de procesos productivos: Se priorizan materiales con baja energía de fabricación, producción local y cadenas de suministro más cortas.
- Regeneración en lugar de mitigación: No alcanza con reducir daño. El diseño pasa de minimizar impacto a generar efectos positivos medibles dentro de ecosistemas productivos.
- Diseño para longevidad y reparación: Se priorizan materiales durables, modulares y fáciles de mantener.
La innovación considera infraestructura disponible, capacidad industrial y separación de componentes, por lo que se diseñan productos que pueden desmontarse y reintegrarse a flujos productivos existentes.
De acuerdo con Circular economy in the built environment: A research framework, la incorporación de principios circulares en la selección de materiales reduce significativamente la huella ambiental del sector productivo.
Materiales reciclados, reutilizados o cultivados redefinen lo que se considera “premium”.
La estética deja de asociarse exclusivamente a lo nuevo o lo escaso y comienza a integrar criterios de responsabilidad ambiental y coherencia ética.
Proceso de experimentación y prototipado
La experimentación material es el núcleo donde hipótesis, errores y ajustes constantes permiten descubrir límites y aplicaciones inesperadas.

El prototipado en cualquier proyecto de diseño funciona como puente entre investigación y producción.
No se trata de validar una forma final, sino de explorar comportamientos, resistencias, texturas y reacciones del material en condiciones reales.
Los laboratorios de materiales, tanto en universidades como en estudios o empresas, realizan pruebas de resistencia, conductividad, biodegradabilidad o flexibilidad antes de escalar a producción.
La impresión 3D reduce tiempos entre idea y prueba física, ya que permite experimentar con biopolímeros, compuestos reciclados o mezclas híbridas sin necesidad de moldes industriales costosos.
El error no se interpreta como retroceso, sino como dato.
Cada iteración ajusta composición, proporciones o procesos de fabricación. Esto convierte la experimentación en metodología y consolida una lógica de aprendizaje continuo.
La innovación material redefine el diseño contemporáneo porque altera su punto de partida. El proyecto ya no comienza únicamente en la forma ni en la función, sino en la materia misma.

En este escenario, el diseñador contemporáneo no selecciona materiales disponibles. Investiga, experimenta y participa en su desarrollo. Trabaja con datos, colabora con especialistas y comprende la dimensión de cada decisión material.
Por sobre todo, el diseñador comprende que el futuro del diseño depende, en gran medida, de cómo decidimos transformar la materia hoy.
¿Querés saber sobre la innovación material y sus aplicaciones a todo tipo de proyectos creativos?
Conocé más sobre la Licenciatura en Diseño Industrial

